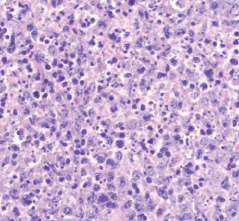
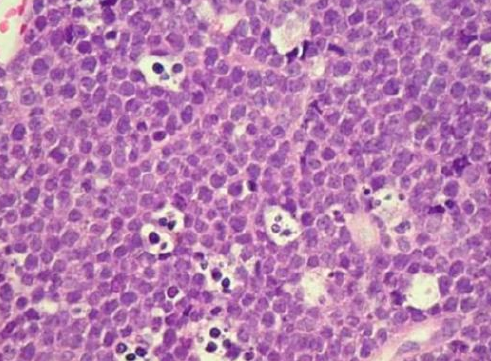

Hematologic Disorders
需要切片
Thalassemia 地中海/海洋性貧血
- α-Thalassemia
- α 出問題, 只有 4β 或 2β2δ
- 嚴重,易死胎
- β-Thalassemia
- β0: 較常見,完全無 β
- β+: 較少見, β 少
- 症狀
- Sunrise skull bone (Hair-on-end)
- 造血細胞/ 骨增生
- 長骨骨隨增生
- 扁平骨變寬
- 血色素沉積: 心、胰、脾


Myelodysplastic syndrome(MDS,骨髓發育不良症候群)
- 如果發展成 Acute leukemia → gingival hyperplasia

Acute monocytic leukemia (AML-M5)
- 最常侵犯口腔的 leukemia
- 血小板減少 → 出血
- 病灶在骨隨
- 腫瘤細胞增生,取代正常細胞甚至破壞骨質
- starry sky pattern
- 星星:macrophages
- 夜空:核濃染的lymphoid cells其中的macrophage,其細胞質內含有apoptotic bodies
- 代表是high grade的lymphoma
- 兒童、年輕人


Kikuchi-Fujimoto disease
- 淋巴結發炎壞死
- Necrosis: 砂粒狀,粉粉的
- nuclear dust: 核破碎的髒東西
- Histiocytes: 結締組織macrophage,CD68, CD163
Cat Scratch Disease
- Granulomas 但一堆 neutrophil
Kimura disease
eosinophils 跑到 Lymph Follicle
- 亞洲年輕的成年男性 (20-30y)
- 深層病灶,淋巴、唾液腫
- 血管增生,型態正常
- 抽血 eosinophils 升高
- IgE-positive mast cell
Epithelioid Hemangioma
eosinophils 跑到 Lymph Follicle
- 男女差不多 (30-50y)
- 淺層病灶,淋巴唾液較少腫脹
- 血管增生,但圓胖內皮 → 墓碑
- 抽血無 eosinophils 升高
Castleman disease
- Onion skin: 淋巴圍血管,一圈又一圈
- 血管壁退化 → hyalinized walls
- Paraneoplastic Pemphigus 可能引發
- HHV 8, IL6

Rosai-Dorfman disease
- 大 Histiocytes 吃周圍 lymphocyte

再來是惡性
Lymphoma
-
口內
- Diffuse Large B-cell Lymphoma (DLBCL)
-
唾液腺
- Mucosa-Associated Lymphoid Tissue (MALT)
-
與免疫低下無關
- Hodgkin Lymphoma (HL)
- DLBCL
- Burkitt Lymphoma
Diffuse Large B-cell Lymphoma (DLBCL)
- 成人口內最常見 Lymphoma (20%)
- 40-50y
- 快速增長,並在淋巴結及其他器官(例如肝臟、脾臟或骨髓)形成腫瘤。
- IHC: BCL6, CD10, MUM1
MALT lymphoma
- Sjogren syndrome 的衍生疾病。
- 好發: Parotid gland
- Helicobacter pylori 相關
- Russell body (From plasma cell)

Burkitt lymphoma
B lymphocyte 的惡性腫瘤
- 分類
- Endemic(地區型 African type): 下顎組織腫脹、腎臟、腎上腺、卵巢
- Sporadic (偶發型): 腹腔
- HIV-associated type
- EVB related
- Endemic 100%
- Sporadic 15-20%
- HIV: 25%
- t(8;14)(t 代表 translocation ), c-MYC 轉位到十四對染色體的 IgH 免疫球蛋白重鏈基因的位置
- c-MYC: Light zone 跟 TFH 結合存活表現
- c-MYC 大量產生 → 增生
- Ki-67(+)
- 口腔常出現
- 年輕
- 侵犯性強,化學治療敏感
- starry sky pattern
Plasmablastic Lymphoma
- EBV related
- 年紀大
- 淋巴結外
- IHC:
- Plasma cell marker: CD38, CD138, CD97a
Extranodal NK/T Cell Lymphoma
- EBV related (100%)
- 淋巴結之外的 NK/T cell 所發展出來的
- 長在鼻中線
- 圍著血管長,侵犯血管 (尤其是動脈)
- 造成大區域缺血壞死
- 侵犯性強,化學治療不敏感 → 預後不佳,大部分病歷都在診斷後三年內過世


Mycosis Fungoides
- CD4 T cell
- 侵犯上皮
Solitary Plasmacytoma 單一漿細胞瘤
過多免疫球蛋白堆積在細胞質
- 分類
- 侵犯骨頭(osseous)
- 常發生在脊椎(vertebral column)
- 10~20 年後可能進展成多發性骨髓瘤(multiple myeloma)
- 侵犯軟組織(extraosseous)
- 常發生在上呼吸道(鼻竇、鼻咽)、肺部、口腔。
- 局限於上述位置,很少進展成多發性骨髓瘤
- 可以通過局部切除或放射線治療
- 侵犯骨頭(osseous)
- 非典型漿細胞(atypical plasma cells)
- 細胞質較多且偏藍紫色
Langerhans Cell Histiocytosis
- Langerhans cell 增生的腫瘤
- BRAF
- 骨侵蝕,從上皮往下長
- 15y ↓,男女差不多。
- 蝕骨
- IHC:
- HLA-DR: 來自 MHC II
- S-100
- CD1a
- CD-207(langerin)
- punched out, scooped out


- 一堆 Eosinophil
- Langerhans Cell: Coffee been 細胞核
- punched out
- 邊緣清晰、圓形或類似「穿孔」的骨病變
multiple myeloma
-
骨破壞
-
蛋白尿
-
punched out

-
Plasma cell 大小不一
-
κ chain 超多 (10:1) → 來自單株
-
可能表現 CD79a, CD56

- Amyloidosis (澱粉狀病變)
- 大舌頭,節結狀
- 眼睛 Waxy plagues
- 堆在 Blood vessel 周邊

Oral Graft versus Host Disease (GVHD)
- 骨髓移植造成
- 急性 (3 月內)
- 移植 T cell 攻擊組織
整理
- Lymphoma 和 EBV
- Burkitt Lymphoma
- Hodgkin Lymphoma
- NK/T-Cell Lymphoma
- Lymphoepithelial carcinoma
- 成人最常見的 lymphoma: Diffuse large B cell lymphoma